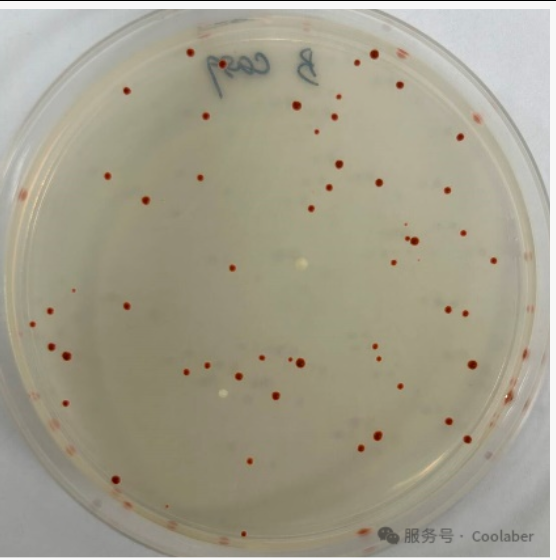

01
产品速览
SD/-Ura with Agar (Ade敲除筛选用)(货号:PM3272)是一种固体培养基,主要为Minimal SD Base (YNB和葡萄糖的混合物)与缺陷氨基酸混合物混合而成。主要用于ADE基因敲除筛选实验使用。
DO Supplement -Ura (Ade敲除筛选用)(PM3270)是Ura缺陷型氨基酸混合物(包含核苷酸)的统称。使用时需要将该缺陷型氨基酸混合物添加到Minimal SD Base(YNB和葡萄糖的混合物)中配制成缺陷型明确的筛选培养基。主要用于ADE基因敲除筛选实验使用。
应用场景
02
当使用基因编辑技术对酵母菌株中的ADE基因进行敲除、突变或者沉默操作时,可以使用该培养基培养菌株,通过观察菌落是否变红来判断基因编辑是否成功。同时,可以通过统计菌落变红与不变红的数量,来确定基因编辑效率,为开发酵母菌株基因编辑方法提供帮助。
03
酵母突变菌株变红原理
酵母ADE基因缺失或突变的菌株培养时间过长时,平板上的Adenine被消耗完毕后,酵母将通过自身代谢途径合成Adenine,但是由于ADE基因失活无法合成Adenine,导致中间产物P-ribosylamino imidazole (AIR)在细胞中积累而使菌落变红(图1)。
往期回顾
